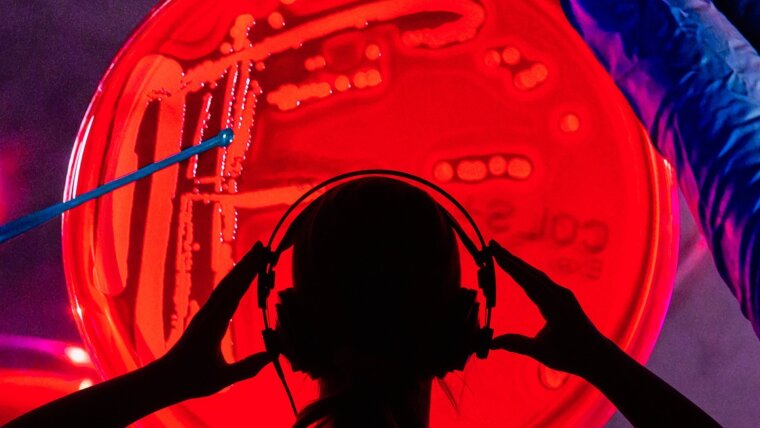
Spectroscopic analysics of a bacteria culture in the lab

Advanced Spectroscopic Methods for Biomedicine, Multimodal Bioimaging & AI-assisted Spectroscopy, Integrated Photonic Diagnostics & Smart Lab-on-a-chip.
Spectroscopic analysics of a bacteria culture in the lab
Image: Jens Meyer (University of Jena)
The ACP key research area Biophotonics & Optical Health Technology focuses on applying light-based techniques to enhance medical diagnostics, treatment, and research. Advanced Spectroscopic Methods for Biomedicine utilize the interaction of light with biological tissues to provide detailed molecular insights, aiding in early disease detection and monitoring. Coupled with Multimodal Bioimaging & AI-assisted Spectroscopy, this field enables highly precise imaging and analysis, while Integrated Photonic Diagnostics & Smart Lab-on-a-chip technology offer compact, real-time diagnostic platforms that integrate photonics for faster, more accurate health assessments and personalized medicine.

















